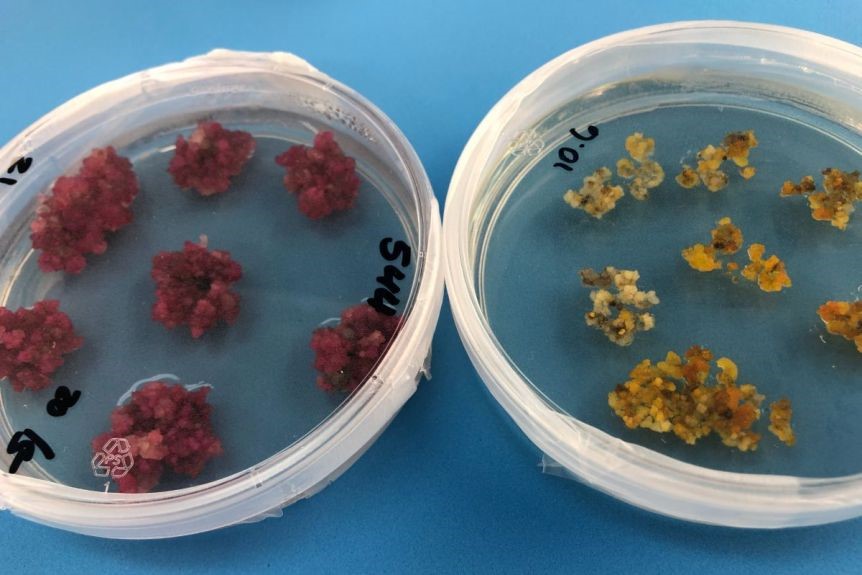

A CSIRO kutatói fantasztikus felfedezést tettek. A szokványos ruhaipari eljáráshoz képest Ők most néhány lépés kihagytak és egyből színes növényi szöveteket kaptak petricsészékben. Ezzel új lehetőségeket teremtve a fentartható divat és mindezek által saját magunk számára is.
Történt ugyanis, hogy géntechnikai módszereket használva a kémiai színezőanyagokat elhagyva színes növényi szöveteket állítottak elő Canberrában. Káprázó színekben – az élénk sárgától a mély liláig -, tündököltek a petricsészék. Colleen MacMillan által vezetett kutatócsoport változtatott a gyapot molekuláris színkódján, géneket adtak hozzá, hogy színes növényt – és ezáltal színes pamutot – kapjanak. A módosított színes géneket dohánynövényekbe ültették, amiknek a levelein színes foltok jelentek meg, ezzel is jelezve a kísérlet sikerességét. Az ideális eredmény pedig az, hogy a növényeken néhány hónap elteltével megjelennek a színes pamutpamacsok.
Forrás: ABC.net
Forrás: ABC.net
Ezzel a fejlesztéssel nagyot változhat a textilipar. Ugyanis alapból a pamut fehér, amit utólag vegyi anyagokkal kezelve színeznek. Ez roppant mód káros mind a környezetre, mind pedig az ebben az iparágban dolgozó személyekre nézve. Így, ha beválik az új innováció, akkor feltehetőleg elhagyhatjuk majd ezeket a káros anyagokat és csökkenteni tudjuk a környezet terhelését.
 Forrás: ABC.net
Forrás: ABC.net
Az már csak hab a tortán, hogy a kutatás másik célja a gyűrődésmentes, rugalmas pamut létrehozása. Megmentve a fölösleges vasalástól az embereket. Sokak idegrendszerére is pozitívan hatna ez a plusz új pamut-tulajdonság. Arról nem is beszélve, hogy a kevesebb áramfogyasztással még környezetkímélőbbek lehetünk.
Forrás: ABC.net
